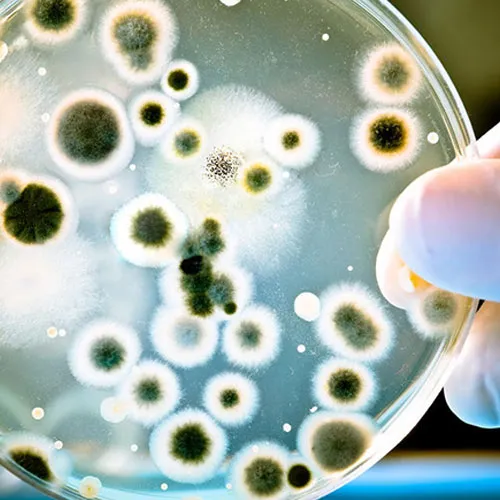
Mold Testing

In the realm of manufacturing, the significance of ensuring product quality and reliability cannot be overstated. One critical aspect that often goes unnoticed but plays a pivotal role is corrosive gas testing. As a trusted supplier of corrosive gas testing services, I have witnessed firsthand the far - reaching applications and benefits of this testing method across various manufacturing sectors.
1. Electronics Manufacturing
The electronics industry is highly sensitive to environmental factors, especially corrosive gases. These gases can cause severe damage to electronic components, leading to malfunctions, reduced lifespan, and increased maintenance costs.
Printed Circuit Boards (PCBs)
PCBs are the backbone of electronic devices. Corrosive gases such as sulfur dioxide (SO₂), hydrogen sulfide (H₂S), and chlorine (Cl₂) can react with the metal traces on PCBs. For example, sulfur - containing gases can form metal sulfides on copper traces, which increase electrical resistance. This can lead to signal degradation, intermittent failures, and even complete circuit breakdown. By conducting Corrosive Gas Testing, manufacturers can identify the vulnerability of PCBs to these gases and take preventive measures such as using protective coatings or choosing more corrosion - resistant materials.
Semiconductor Devices
Semiconductor chips are extremely delicate and require a clean and stable environment. Corrosive gases can penetrate the protective layers of semiconductor devices and react with the silicon or metal components inside. This can cause changes in the electrical properties of the semiconductor, leading to performance degradation or permanent damage. Corrosive gas testing helps semiconductor manufacturers to optimize their packaging designs and select appropriate materials to protect the chips from the harmful effects of these gases.
2. Automotive Manufacturing
The automotive industry is another sector where corrosive gas testing is of utmost importance. Vehicles are exposed to a wide range of environmental conditions, including corrosive gases from exhaust fumes, industrial emissions, and road salts.
Exterior Components
Automotive exterior components such as body panels, bumpers, and trim are constantly exposed to the elements. Corrosive gases can cause rusting and corrosion of metal parts, which not only affects the aesthetic appearance of the vehicle but also compromises its structural integrity. For example, sulfur dioxide in the air can react with iron in the metal parts to form iron sulfates, which accelerate the corrosion process. By subjecting exterior components to corrosive gas testing, automotive manufacturers can evaluate the corrosion resistance of different materials and coatings and select the most suitable ones for long - term durability.
Interior Components
The interior of a vehicle also needs to be protected from corrosive gases. Components such as dashboard materials, seat upholstery, and electrical wiring can be affected by the presence of corrosive gases. For instance, chlorine - containing gases can cause discoloration and degradation of plastic materials. Corrosive gas testing helps manufacturers to ensure that the interior components of the vehicle are resistant to these gases and maintain their quality and functionality over time.
3. Aerospace Manufacturing
In the aerospace industry, where safety and reliability are non - negotiable, corrosive gas testing is a crucial part of the manufacturing process. Aircraft are exposed to a harsh environment, including high - altitude conditions, extreme temperatures, and corrosive gases from jet engine exhaust.
Structural Components
The structural components of an aircraft, such as wings, fuselage, and landing gear, are made of high - strength metals. Corrosive gases can weaken these metals over time, leading to fatigue and potential structural failures. For example, nitrogen oxides in the exhaust gases can react with aluminum alloys, causing pitting corrosion. By conducting corrosive gas testing on these components, aerospace manufacturers can ensure that they meet the strict safety standards and have a long service life.
Avionics Systems
Avionics systems, which are responsible for the navigation, communication, and control of the aircraft, are highly sensitive to environmental factors. Corrosive gases can damage the electronic components in these systems, leading to malfunctions and safety risks. Corrosive gas testing helps to verify the reliability of avionics systems under different gas - exposure conditions and allows manufacturers to take appropriate measures to protect them.
4. Food and Beverage Manufacturing
In the food and beverage industry, maintaining product quality and safety is the top priority. Corrosive gas testing can be used to ensure the integrity of packaging materials and the safety of processing equipment.
Packaging Materials
Packaging materials play a crucial role in protecting food and beverages from contamination and spoilage. However, corrosive gases in the environment can affect the quality of these materials. For example, oxygen and moisture can cause oxidation and corrosion of metal cans, leading to the leakage of food products. By testing packaging materials against corrosive gases, manufacturers can select materials that provide an effective barrier and prevent the ingress of these gases.
Processing Equipment
Food and beverage processing equipment is often made of metal or other materials that can be susceptible to corrosion. Corrosive gases generated during the processing, such as sulfur dioxide used in wine production, can cause damage to the equipment. Corrosive gas testing helps manufacturers to identify the corrosion - prone areas of the equipment and take preventive measures such as regular cleaning, maintenance, and the use of corrosion - resistant coatings.
5. Pharmaceutical Manufacturing
The pharmaceutical industry has strict quality and safety standards. Corrosive gas testing is essential to ensure the stability and efficacy of pharmaceutical products and the integrity of manufacturing equipment.
Drug Packaging
Pharmaceutical products need to be protected from environmental factors to maintain their quality. Corrosive gases can penetrate the packaging materials and react with the drugs, leading to degradation and loss of potency. For example, moisture and oxygen can cause oxidation of certain drugs. By conducting corrosive gas testing on drug packaging, manufacturers can select appropriate materials that provide a stable environment for the drugs and prevent their deterioration.
Manufacturing Equipment
Pharmaceutical manufacturing equipment is made of various materials, including stainless steel and plastics. Corrosive gases generated during the manufacturing process or present in the environment can cause corrosion of these materials. This can lead to the contamination of pharmaceutical products and affect their quality. Corrosive gas testing helps to evaluate the corrosion resistance of the equipment and ensure that it meets the strict hygiene and safety requirements of the pharmaceutical industry.
Advantages of Our Corrosive Gas Testing Services
As a leading supplier of corrosive gas testing services, we offer several advantages to our clients. Our testing facilities are equipped with state - of - the - art equipment that can simulate a wide range of corrosive gas environments accurately. Our team of experienced technicians and scientists has in - depth knowledge of corrosion mechanisms and can provide comprehensive testing reports and analysis.
We also offer complementary services such as Mold Testing and Salt Spray Test to provide a more comprehensive evaluation of product reliability. Our testing services are customized to meet the specific needs of each client and can help them to improve product quality, reduce costs, and enhance their competitiveness in the market.

Conclusion
Corrosive gas testing has a wide range of applications in manufacturing, from electronics and automotive to aerospace, food and beverage, and pharmaceutical industries. By understanding the impact of corrosive gases on products and equipment, manufacturers can take proactive measures to prevent corrosion and ensure the quality and reliability of their products.
If you are a manufacturer looking for reliable corrosive gas testing services, we invite you to contact us for a consultation. Our team is ready to work with you to develop a customized testing solution that meets your specific requirements and helps you to achieve your manufacturing goals.
References
- ASTM International. (2023). ASTM standards related to corrosion testing.
- ISO. (2023). International standards for environmental reliability testing.
- Smith, J. (2022). Corrosion in the Electronics Industry. Journal of Electronic Materials.
- Brown, A. (2021). Automotive Corrosion Prevention and Control. SAE International.
